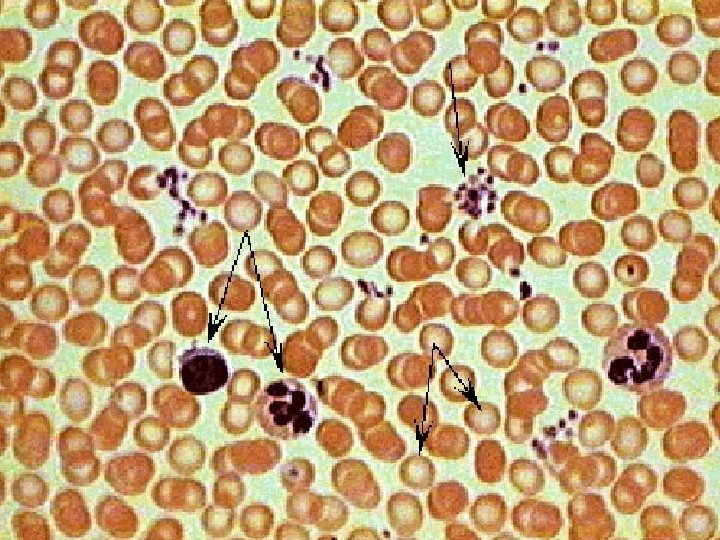

Chapter 4 TISSUES AND MEMBRANES TISSUES 4 Main

Chapter 4 TISSUES AND MEMBRANES

TISSUES • 4 Main types of tissues: – Epithelial tissue • protects the body by covering internal and external surfaces – Connective tissue • supports and connects organs and tissue – Muscle tissue • contains cell material which has the ability to move the body – Nervous tissue • contains cells that react to stimuli and conduct an impulse

Epithelial tissue • Func – cells form a continuous layer covering internal and external body surfaces, provide protection, produce secretions (digestive juices, hormones, perspiration), and regulate the passage of materials across them.

Epithelial tissue – char. and location • A – Covering and lining tissue – cells can be stratified (layered), ciliated or keratinized (hard, nonliving substance. ) – 1. Squamous epithelial cells • Are flat, irregularly shaped cells. • Line the heart, blood and lymphatic vessels, body cavities, and alveoli of the lungs. • Outer layer of skin consists of stratified squamous epithelia cells. These protect the body against microbial invasion.






Epithelial tissue – char. and location – 2. Cuboidal epithelial cells • Cube-shaped cells line the kidney tubules and cover ovaries and secretory parts of certain glands. – 3. Columnar epithelial cells • Are elongated, w/the nucleus generally near the bottom and often ciliated on the outer surface. • Line ducts, digestive tract, parts of the respiratory tract, and glands.







Epithelial tissue – char. and location • B. Glandular or secretory tissue – cells are specialized to secrete matl’s such as digestive juices, hormones, milk, perspiration, and wax. They are columnar or cuboidal shape. 1. Endocrine gland cells – Form ductless glands which secrete their substances (hormones) directly into the bloodstream.

Epithelial tissue – char. and location – 2. Exocrine gland cells • Cells secrete their substances into ducts. Ex. Mammary glands, sweat glands, and salivary glands.

Connective tissue • Function – cells whose intercellular secretions (matrix) support and connect the organs and tissues of the body. • Found almost everywhere w/i the body: bones, cartilage, mucous membranes, muscles, nerves, skin, and all internal organs.

Connective tissue – function • A. Adipose tissue – Stores lipid, acts as filler tissue, cushions, and insulates the body. - Type of loose connective tissue composed of saclike adipose cells; specialized for storage of fat. - Found t/o the body; skin, around the kidneys, w/i padding of joints, and marrow of long bones.



Connective tissue – char and location • B. Areolar (loose) tissue – Tissue surrounds various organs and supports both nerve cells and blood vessels which transport nutrient matl’s to cells and wastes from cells. – Also temporarily stores glucose, salts, and water. – Composed of large, semifluid matrix, w/many different types of cells and fibers.

– Cells – fibroblasts, plasma cells, macrophages, mast cells, WBC. – Fibers – collagen, elastin – Found in epidermis of skin and subcutaneous layer with adipose cells.



Connective tissue – function • C. Dense fibrous tissue – Forms ligaments, tendons, and apoenuroses. • Ligaments – strong, flexible bands or cords which hold bones firmly together at the joints. • Tendons – white, glistening bands attaching skeletal muscles to the bones.

• Aponeuroses – flat, wide bands of tendons holding one muscle to another or to the periosteum (bone covering. ) • Fasciae – fibrous connective tissue sheets that wrap around muscle bundles to hold them in place.

Connective tissue – char and location • Dense fibrous tissue is also called white fibrous tissue b/c it is made from closely packed white collagen fibers. Fibrous tissue is flexible, but not elastic. • Has poor blood supply and heals slowly.


Connective tissue – function • D. Supportive tissue – 1. Osseous (bone) tissue • Comprises the skeletons of the body, which supports and protects underlying soft tissue parts and organs, and also serves as attachments for skeletal muscles. • Char and location – the matrix is calcified by the deposition of mineral salts like Ca. CO 3 and Ca 3(PO 4)2.


Connective tissue – function – 2. Cartilage • Provides firm but flexible support for the embryonic skeleton and part of the adult skeleton. • A. Hyaline – forms the skeleton of the embryo. – Char. and location – found on articular bone surfaces and nose tip, bronchi, and bronchial tubes. Ribs are joined to the sternum by the costal cartilage. Also found in the larynx and rings of the trachea.



Connective tissue – function • B. Fibrocartilage – strong, flexible, supportive substance, found b/w bones and wherever great strength is needed. • Char and location – located w/i the intervertebral discs and pubic symphysis b/w the pubic bones. • C. Elastic cartilage – intercellular matrix is embedded w/a network of elastic fibers and is firm but not flexible. • Char and location – inside the auditory ear tube, external ear, and larynx.



Connective tissue – function – E. Vascular (liquid blood tissue) • 1. Blood – transports nutrient and oxygen molecules to cells and metabolic wastes from cells. Contains cells that function in the body’s defense and in blood clotting. – Char and location – 2 parts: liquid called plasma and solid called blood cells. – Plasma suspends the cells. RBC’s , WBC’s, and platelets (blood clotting, thrombocytes). – Blood circulates w/I the blood vessels (arteries, veins, and capillaries) and t/the heart.

Connective tissue – function – 2. Lymph – transports tissue fluid, proteins, fats, and other matl’s from the tissues to the circulatory system. • Char and location – consists of water, glucose, protein, fats, and salts. • Cellular components are lymphocytes and granulocytes. • Flow in tubes called lymphatic vessels which closely parallel the veins and bathe tissue spaces b/w cells.


Muscle tissue • A. Cardiac muscle – Function – cells help the heart contract in order to pump blood t/ and out of the heart. – Char and location – a striated (having cross-banding pattern), involuntary (not under conscious control) muscle. Makes up the walls of the heart


Muscle tissue – B. Skeletal muscle • Function - are attached to the movable parts of the skeleton. Are capable of rapid, powerful contractions and long states of partially sustained contractions, allowing for voluntary movement. • Char and location – striated, voluntary and skeletal.


Muscle tissue – C. Smooth muscle • Function – provide involuntary movement. • Char and location – nonstriated, involuntary. Makes up walls of digestive tract, genitourinary tract, blood vessels, and lymphatic vessels.


Nervous tissue • Neurons – Function – react to stimuli • 1. Irritability – ability of nerve tissue to respond to environmental changes. • 2. Conductivity – ability to carry a nerve impulse (message). – Char and location – have branches t/which various parts of the body are connected and their activities coordinated. They are found in the brain, spinal cord, and nerves.



MEMBRANES • A membrane is formed by putting two thin layers of tissue together. The cells in the membrane may secrete a fluid. • Types: – Epithelial membranes are classified according to secretions produced: • Mucous membranes • Serous membranes – Connective tissues support and connect the organs and tissues


Mucous membranes – Line surfaces and spaces that lead to the outside of the body – Line the respiratory, digestive, reproductive, and urinary systems. – Produce mucus, which lubricates and protects the lining. • Mucosae – Respiratory mucosa – lines respiratory tract. – Gastric mucosa – lines the stomach. – Intestinal mucosa – lines the small and large intestines.

Serous membrane • Double-walled membrane that produces a watery fluid and lines closed body cavities. • Fluid – serous fluid. • Outer part of the memb that lines the cavity is the parietal memb. • The part that covers the organs w/i is the visceral membrane. • The fluid produced allows organs w/i to move freely and prevents friction.

Serous membrane • The serosa is given to the specific serous membranes. – Pleural memb – lines the thoracic or chest cavity and protects the lungs. The fluid is called pleural fluid. – Pericardial memb – lines the heart cavity and protects the heart. The fluid is called pericardial fluid. – Peritoneal memb – lines the abdominal cavity and protects the abdominal organs. The fluid is called peritoneal fluid.

Cutaneous membrane • Skin • A specialized type of epithelial membrane.

Connective membrane – Synovial membrane – lines joints cavities. • Secrete synovial fluid which prevents friction inside the joint cavity.

ORGANS AND SYSTEMS • Organs are groups of tissues joined together to perform a single function • An organ system is a group of organs that together perform a specific function

DEGREE OF TISSUE REPAIR • Damaged tissues are repaired continually • Depending on the type and location of injury, some tissues are repaired quickly

PROCESS OF EPITHELIAL TISSUE REPAIR • There are two types of epithelial tissue repair: – Primary repair involves skin where there is no infection present – Secondary repair occurs in large, open wounds with tissue loss
- Slides: 62